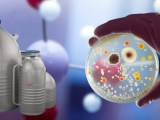

Unveiling the Wonders of Nickel Conductive Paste/Paint: Bringing Connections to Life
November 25, 2023Introduction:
In electronics, a hidden hero is crucial in making connections possible – enter nickel conductive paste/paint. This unassuming material, often overlooked, is a vital component in creating conductive pathways that allow electronic devices to function seamlessly. Let’s dive into the world of nickel conductive paste/paint and discover how it brings connections to life in a language that’s easy to understand.
Composition and Purpose:
Nickel conductive paste/paint is a specialized material containing tiny particles of nickel, a versatile metal known for its excellent conductivity. The nickel particles are suspended in a carrier fluid, creating a paste or paint-like substance. The primary purpose of this concoction is to provide a conductive layer on surfaces, facilitating the flow of electricity.
Applications:
- Printed Circuit Boards (PCBs): One of the main applications of nickel conductive paste/paint is manufacturing printed circuit boards (PCBs). These are the backbone of electronic devices, and nickel paste is used to create conductive traces that connect different components on the board. It forms the electrical highways that allow signals to travel between various device parts.
- Flexible Electronics: With the rise of flexible and wearable electronics, nickel conductive paste/paint has found a new realm of applications. It is used to create conductive patterns on flexible substrates, enabling the development of bendable and stretchable electronic devices.
- Solar Cells: In renewable energy, nickel conductive paste plays a role in producing solar cells. It is used to create contacts on the surface of solar cell wafers, allowing for the efficient collection and transfer of electrical energy generated by sunlight.
- Electronic Components: Nickel conductive paste is applied to produce various electronic components, including resistors, capacitors, and inductors. It aids in creating the necessary connections and pathways for these components to function as intended.
Advantages:
- High Conductivity: Nickel is chosen for its excellent conductivity, making the paste/paint an effective material for creating reliable electrical connections.
- Adhesion: Nickel conductive paste/paint exhibits good adhesion to various substrates, ensuring the conductive layer stays firmly attached to the surface.
- Temperature Resistance: This material is designed to withstand various temperatures, ensuring stability and functionality in diverse electronic applications.
Conclusion:
While nickel conductive paste/paint may not grab the spotlight in electronics, its role is undeniably vital. From enabling the creation of intricate circuits on PCBs to contributing to the flexibility of modern electronic devices, this unassuming material forms the backbone of our interconnected world. As technology advances, nickel conductive paste/paint applications will likely expand, further solidifying its status as a silent yet indispensable player in the electronics industry.